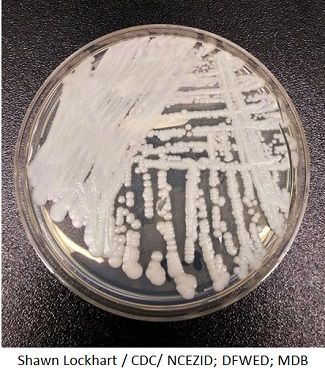

Healthcare Associated Infections (HAI)
Latest News
Latest Videos

CME Content
More News

After receiving treatment with ibrexafungerp, a patient with esophageal candidiasis gradually improved and by day 54 he was completely asymptomatic.

Investigators from the University of Sherbrooke found some bacterial strains of C diff are likely associated with mortality in C diff infection, specifically, NAP1/BI/R027.

An 18-year retrospective cohort study of 130 hospitals in the US Veterans Health Administration system revealed a significant reduction in cases of hospital-onset candidemia. But what caused the drop?

A new study has uncovered that only one-third of patients who present to the emergency department with suspected UTI have evidence of infection, yet the majority receive antibiotics.

Contagion® caught up with Christian Lillis, executive director of the Peggy Lillis Foundation, to hear about the organization’s recent efforts, what obstacles it’s facing, and how providers can help.

New York Times coverage of the problematic “superbug” generates quite a response.

Are the threats of CMS financial penalties creating tunnel vision for certain hospital-associated conditions?

Investigators are now exploring whether the “health care-associated” label for pneumonia is actually doing more damage than anticipated.

Findings of 2 recent studies illustrate the often-preventable risks associated with surgery.

A new study of cockroaches collected from an Iranian hospitals sheds light on how these insects can carry and spread resistant microbes.

The study found that that acute care hospitals with a 20% reduction in fluoroquinolone or third and fourth generation cephalosporins had a “corresponding decrease” in hospital-onset C diff.

Clostridium difficile rates in stem cell transplant patients are approximately 9 times greater than in hospitalized patients, with rates about twice as high in allogeneic vs autologous transplants.

Staph infections aren't going away and now a new report says we're not doing as well as we think.

It’s become a serious global health threat, and now a new study investigating 9 cases of Candida auris infections in Brooklyn highlights the importance of quickly identifying these fungal infections.

State health care-associated infection reporting laws are critical for surveillance, but are they bogging down infection prevention programs?

Workers in a variety of industries—not just health care—face significant risk of infection at work. A new study finds a number of new risks are emerging, adding to the need for vigilance.

Investigators at Memorial Sloan Kettering Cancer Center determined valganciclovir was the preferred first-line preemptive therapy to prevent cytomegalovirus in patients following an allogeneic hematopoietic cell transplantation.

The length of mechanical friction applied to the needleless connector of a central venous catheter before insertion may make a difference in rate of disinfection.

Investigators detected no relevant change in systemic concentrations of 9 probe drugs when rezafungin was dosed concomitantly.

Are we ignoring non-C diff infected rooms and promoting contamination?

The findings echo the guidelines published by IDSA/SHEA in 2018.

As outpatient medical care becomes more common, are we forgetting the role of infection control?

Hospital-onset sepsis is twice as deadly as community-onset sepsis and increases the risk of death 3-fold, according to the results of a cohort study comprising 2.3 million adult patients.

Hospital-acquired conditions fell 13% between 2014 and 2017, according to a new report from the Agency for Healthcare Research and Quality.

Sink drains near toilets in hospital rooms could be reservoirs of antibiotic-resistant bacteria, a new study suggests.